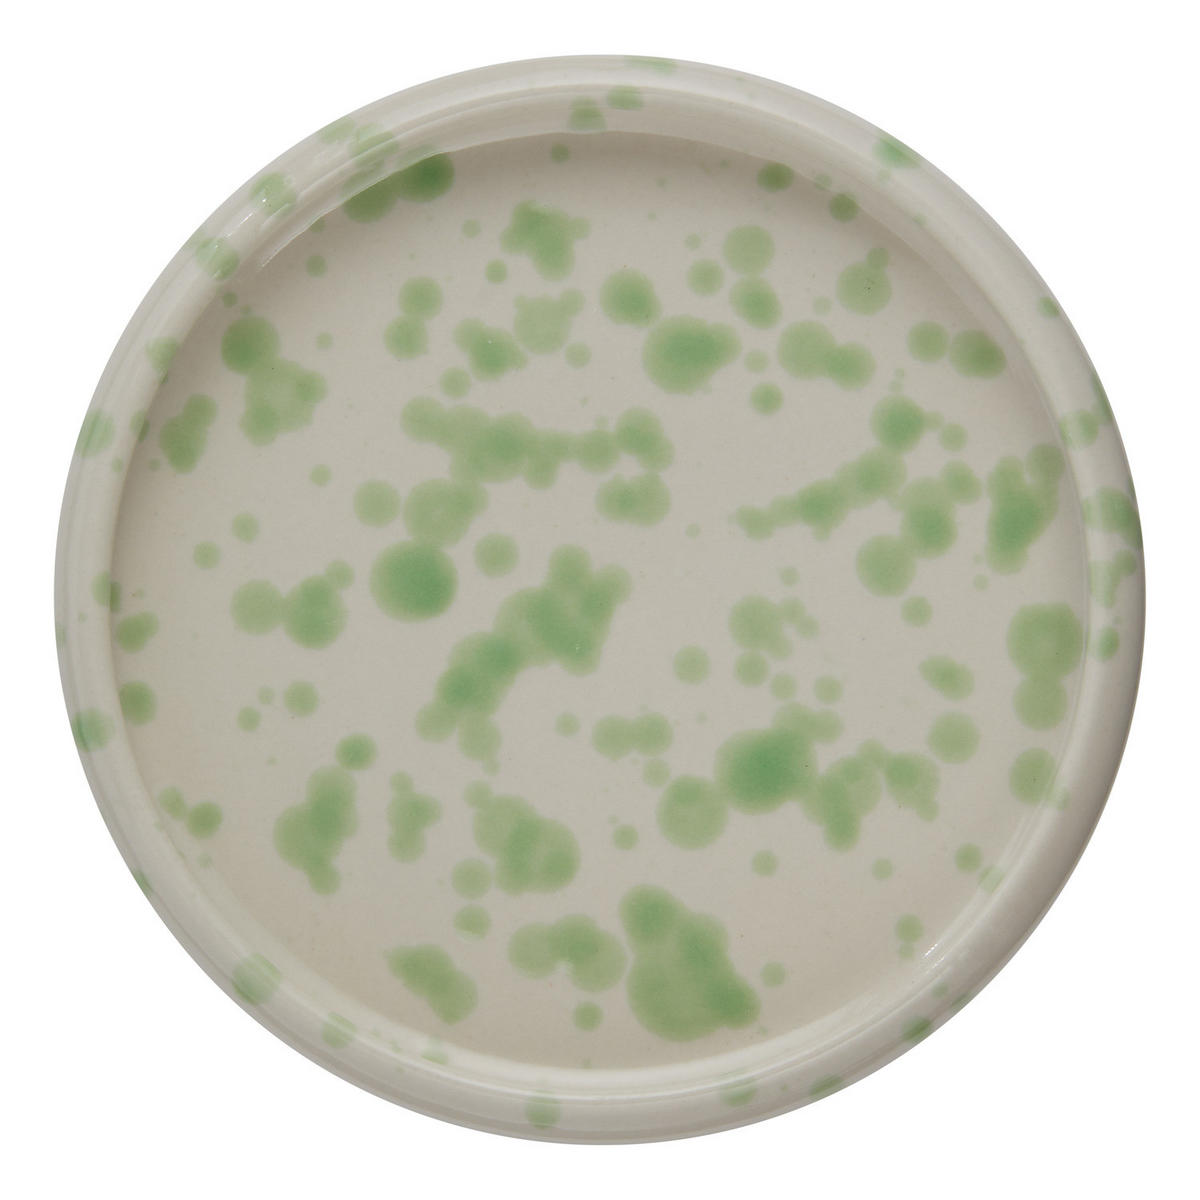
APPETIZERTELLER Boogy Splash - Mintgrün, Keramik (12/12/2cm) - Butlers

Lebendige Tupfer tanzen auf dem Boogy Splash Appetizerteller. Das minimalistische Geschirr aus hochwertigem Steinzeug ist organisch geformt und greift, ganz modern, die abgerundete Form eines Frisbees auf. Dieser besondere Look und die neutrale Farbwelt machen die Teller und Schalen der Boogy Splash Geschirrserie zu einem Statement Pieces auf dem gedeckten Tisch. Verschiedene Farben erhältlich, perfekt für dein individuelles Mix & Match.